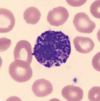
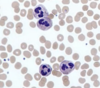
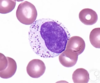
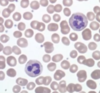
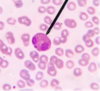

Histology: Cardio, Lymph, Eyes, Ears Flashcards
(52 cards)
Which Leukocyte is shown?
Basophil
Which leukocyte is shown?
Neutrophil
Which leukocyte is shown?
Lymphocyte
Which leukocyte is shown?

Basophil
Which leukocyte is shown?
Neutrophil
Which leukocyte is shown?

Monocyte
Which leukocyte is shown?
Eosinophil
ID Tissue Type and all Structures noted

Lymph Node
- Germinal Center
- Lymph Nodule
- Capsule
- Maybe Trabeculae???
- Sinusoid
- Dr. Jones doesnt know
- Cortex (deep to this is medulla)
ID Tissue and Structures noted

Tonsil
- Germinal Center
- Nodule
- Epithelium
*Crypt not shown, but know it (refer to other tonsil slide)
Imagine a Tonsillar crypt of a Tonsil tissue. Check the back for you answer.

ID tissue and Specific structures labeled

Spleen
- Lymphatic Nodule
- Germinal Center
- Capsule
- Red Pulp
*keep in mind: splenic cord, venous sinus, trabecula
ID tissue and specific strucutures labeled

Spleen
- Splenic cord
- Venous Sinus
ID Structures shown
- Heart endocardium
- Subendocardial layer
- purkinje fibers shown
- Myocardial Layer
ID different structures shown
- Epicardium
- Mesenchymal outer layer
- Connective tissue
- Autonomic nerves
- Myocardium
ID structure shown at pointer
Lymph Vessel
- Notice how the blood is “tacky”, stuck on the sides. It has a pale red color due to H&E, but there are no clear RBCs because lymph is just plasma and other protein stuff
ID structures in the slide
- Capillary
- Various sized arterioles
ID structures shown
Sinusoid capillary with surrounding adipocytes and Hematopoetic cells
*sample from bone marrow i believe*
ID structure shown.
What is at the pointer?
Thymus
Hassal’s Corpuscle
ID structure shown at pointer.
What is the structure above and to the left of the pointer?
- Arteriole
- Vein
ID structure shown at pointer
- Purkinje Fibers
ID the structure shown
- Purkinje fibers
ID structure shown at pointer
- Epicardium
ID structures shown
- Endothelium
- Subendocardium
- Purkinje fibers
- Myocardium
ID structures shown at the pointer and above the pointer to the right
- Vein
- Artery























